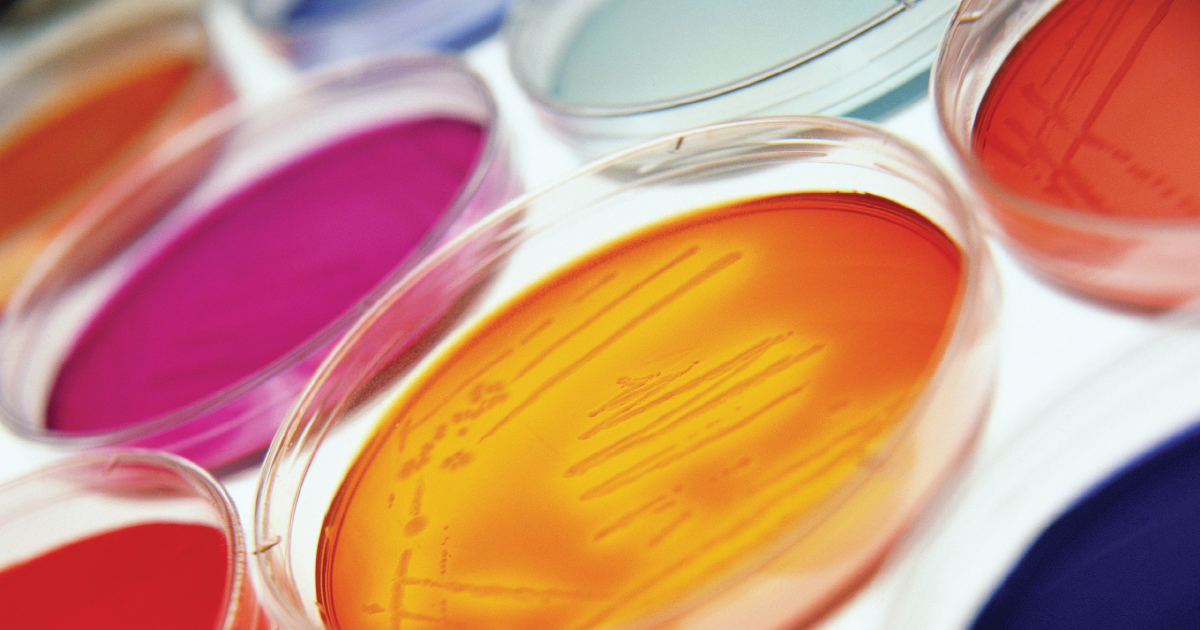

Major Types of Blood Disorders
Throughout history, blood has been connected to the thought of life. Healthy blood will make all the difference in the human body because it is a type of living tissue that consists of both liquids and solids. Blood disorders can be caused by simple genetic inheritance or by manmade occurrences such as through medicines, lack of proper diet, or disease. When it comes to blood disorders, they typically affect the red blood cells, white blood cells, platelets, or plasma.
Learn about the major types of blood disorders what part of blood they affect now.
Red Blood Cells: Anemia

Individuals with anemia have a low red blood cell count in their blood-stream, which can cause various types of deficiencies. The main purpose of a red blood cell is to act like a supply agent. Specifically, they carry oxygen from the lungs throughout the body. Severe anemia can cause pale skin, shortness of breath, and fatigue. Deficiencies in both iron and vitamin B12 can result in different types of anemia, as these nutrients are necessary in order to make more red blood cells and to keep nerve endings functioning correctly.
Read about an iconic form of anemia next.
Red Blood Cells: Sickle Cell Anemia

Sickle cell anemia is a genetically inherited form of anemia characterized by irregularly shaped red blood cells that do not function properly. Instead of having a round shape like healthy red blood cells, sickled red blood cells are rigid and shaped like a crescent moon. The presence of sickle cells in a patient's blood causes a crowding out of healthy red blood cells. These sickle cells have a tendency to accumulate and stick together in the blood vessels, causing an obstruction in blood flow. When this occurs, the affected individual will have episodes of severe pain due to oxygen deprivation to the tissues around the obstruction. Sickle cell anemia patients are prone to contracting infections frequently. This occurs because an organ called the spleen, which is part of the immune system, becomes overwhelmed with sickle cells and is unable to perform its usual immune defense functions as a result. The only possible cure for sickle cell anemia is a bone marrow transplant. Treatment otherwise focuses on the prevention of complications and symptom management.
Learn about another blood disorder that affects the red blood cells now.
Red Blood Cells: Thalassemia

Thalassemia is an inherited blood disorder where the body does not produce enough functioning hemoglobin. There are two classifications of thalassemia based on the two proteins that make up hemoglobin. Alpha thalassemia happens when a patient has a mutation or absence in the gene or genes responsible for encoding the instructions on how to make a protein called alpha globulin. Beta thalassemia occurs when there is a mutation or absence in the gene that contains the instructions for producing the beta globulin protein.
Symptoms of thalassemia include fatigue, shortness of breath, bone deformities, growth failure, and yellow skin or jaundice. This disorder is diagnosed using a blood test. Anemia is usually present along with red blood cells that are small and shaped abnormally. Thalassemia treatment focuses on maintaining healthy levels of hemoglobin-related components in the patient's blood. This is usually managed by frequent blood transfusions and folate supplements.
Get familiar with another blood disorder that affects red blood cells now.
Red Blood Cells: Malaria

Mosquitos, which are annoying creatures normally, can also be quite dangerous as they can carry a parasite that has the potential to cause malaria, another blood disorder. In response to the parasite injected into the individual's bloodstream, red blood cells will rupture, which will cause chills, fever, and eventually organ damage. Malaria is best prevented rather than treated, especially in rural areas of the world by adding mosquito nets when sleeping, staying away from still water sources, and applying insect repellent in its various forms. Currently, there are two important antimalarial drugs that can assist malaria patients.
Uncover details on another red blood cell disorder now.
Red Blood Cells: Polycythemia Vera

Polycythemia vera, though the causes are unknown, happens when the body makes too many red blood cells. Typically, excess red blood cells do not create problems in the body, however, in some individuals it may result in blood clots forming in the body, stopping the flow of blood to vital areas, and other patients may experience other symptoms such as thickening of the blood that results in bleeding. If left untreated, polycythemia vera can process into more serious forms of cancer such as myelofibrosis.
Keep reading to learn about blood disorders that affect white blood cells next.
White Blood Cells: Lymphoma

Lymphoma, though it is a major blood disorder, is better known as a form of cancer in white blood cells start multiplying and spreading in the bloodstream abnormally. Most individuals believe extra white blood cells are a good thing because they are well known to help fight against infection. However, abnormal white blood cells do not behave the same as healthy white blood cells and will actually impede against normal bodily function. Treatment for this cancer typically includes radiation therapy as well as chemotherapy.
Continue to uncover more blood disorders that affect white blood cells now.
White Blood Cells: Myelodysplastic Syndrome
Myelodysplatic syndrome is actually a family of blood cancers that affect the bone marrow, which makes different blood cells, including red blood cells, white blood cells, and platelets. For the most part, this syndrome progresses quite slowly and does not often have symptoms in its early stages. Symptoms that can appear later, however, include unusual bleeding, pale skin, shortness of breath, bruises, and chronic fatigue.
Though it is slow, myelodysplastic syndrome does have the potential to suddenly transform into a severe form of leukemia if it is not appropriately treated and monitored. Treatments typically include blood transfusions, stem cell transplants, chemotherapy, or a combination of the three.
Keep reading and learn about the next blood disorder that affects the affected individual's white blood cells.
White Blood Cells: Leukemia

Leukemia is probably one of the most well-known forms of cancer. This type of cancer develops inside an individual's bone marrow. White blood cells multiply inside of the bone marrow, hindering the growth of new red blood cells and platelets into the system. Platelets are the cells that help stop bleeding should an individual get cut or bruised. Bone marrow transplants can be used as a form of treatment for leukemia, as a method to encourage new and healthy growth.
Keep reading for more on blood disorders that affect white blood cells now.
White Blood Cells: Multiple Myeloma

Multiple myeloma is a type of blood cancer that develops from the plasma cells or a type of white cell in an individual's blood responsible for the production of antibodies. Because plasma cells are made in an individual's bone marrow, multiple myeloma causes these malignant plasma cells to build up in the bone marrow and crowd out healthy cells. The cancerous plasma cells produce toxic proteins in the place of the antibodies they should be producing. These toxic proteins can cause a dangerous reduction in kidney function. Symptoms that commonly manifest in multiple myeloma patients include nausea, loss of appetite, mental fogginess, frequent infections, weakness in the legs, bone pain, constipation, fatigue, weight loss, and excessive thirst. A multiple myeloma diagnosis is made using blood tests, urinalysis, bone marrow biopsy, and imaging tests. In asymptomatic individuals affected by this type of cancer, treatment may not be needed until further progression is detected. For more advanced stages of multiple myeloma, treatment may involve a bone marrow transplant, chemotherapy, targeted therapy, biological therapy, radiation therapy, and corticosteroids.
Learn about a blood disorder affecting platelets next.
Platelets: Thrombocytopenia

Thrombocytopenia is a blood disorder characterized by a deficiency of thrombocytes, platelets responsible for blood clotting. This disorder occurs when too many of an individual's platelets are being destroyed, or when the bone marrow does not produce enough thrombocytes or platelets. A healthy individual's blood contains between 140,000 to 440,000 platelets per microliter, and any individual with a platelet count under 140,000 is considered to have thrombocytopenia. Symptoms of this condition include tiny red dots on the skin of the lower legs called petechiae, excessive bruising with minor trauma, bleeding gums, heavy menstrual periods, blood in the urine, and blood in the stool. A diagnosis is made using a blood test that counts the number of platelets present in a patient's blood. Treatment of thrombocytopenia depends on the underlying cause of the disorder. Careful avoidance of injuries and frequent platelet transfusions are common treatments for individuals affected by difficult cases of thrombocytopenia.
Read about blood disorders related to plasma next.
Plasma: Sepsis

The plasma part of the blood is actually the liquid portion, and it is a mixture of water, sugar, fats, proteins, and salts. The main purpose of plasma is to transport both white and red blood cells throughout the body as well as vital nutrients and hormones. Sepsis occurs when an infection from somewhere throughout the body enters the bloodstream and spread rapidly often attacking other functions and organs, eventually causing organ failure.
Continue reading to understand more about blood disorders that affect plasma now.
Plasma: Hemophilia

Hemophilia is an uncommon disorder in which an individual's blood does not clot the way it should because it doesnât have the required blood-clotting proteins or clotting factors. Hemophilia is typically a genetic disorder patients inherit from their parents, but it can occur spontaneously as well. Symptoms that commonly occur in individuals with hemophilia include excessive bleeding after injuries, unusual bleeding after vaccinations, blood in the stool or urine, nosebleeds with an unknown cause, and excessive bleeding after dental work or surgery. When someone with hemophilia bumps their head, the dangerous complication of bleeding into the brain can occur. A diagnosis of hemophilia is made with a blood test. Treating hemophilia is based on the replacement of whichever clotting factor is deficient through an intravenous infusion. Replacement clotting factor for treatment can be obtained from blood others have donated, or it can be done with recombinant clotting factors or laboratory created products similar to human clotting factor.